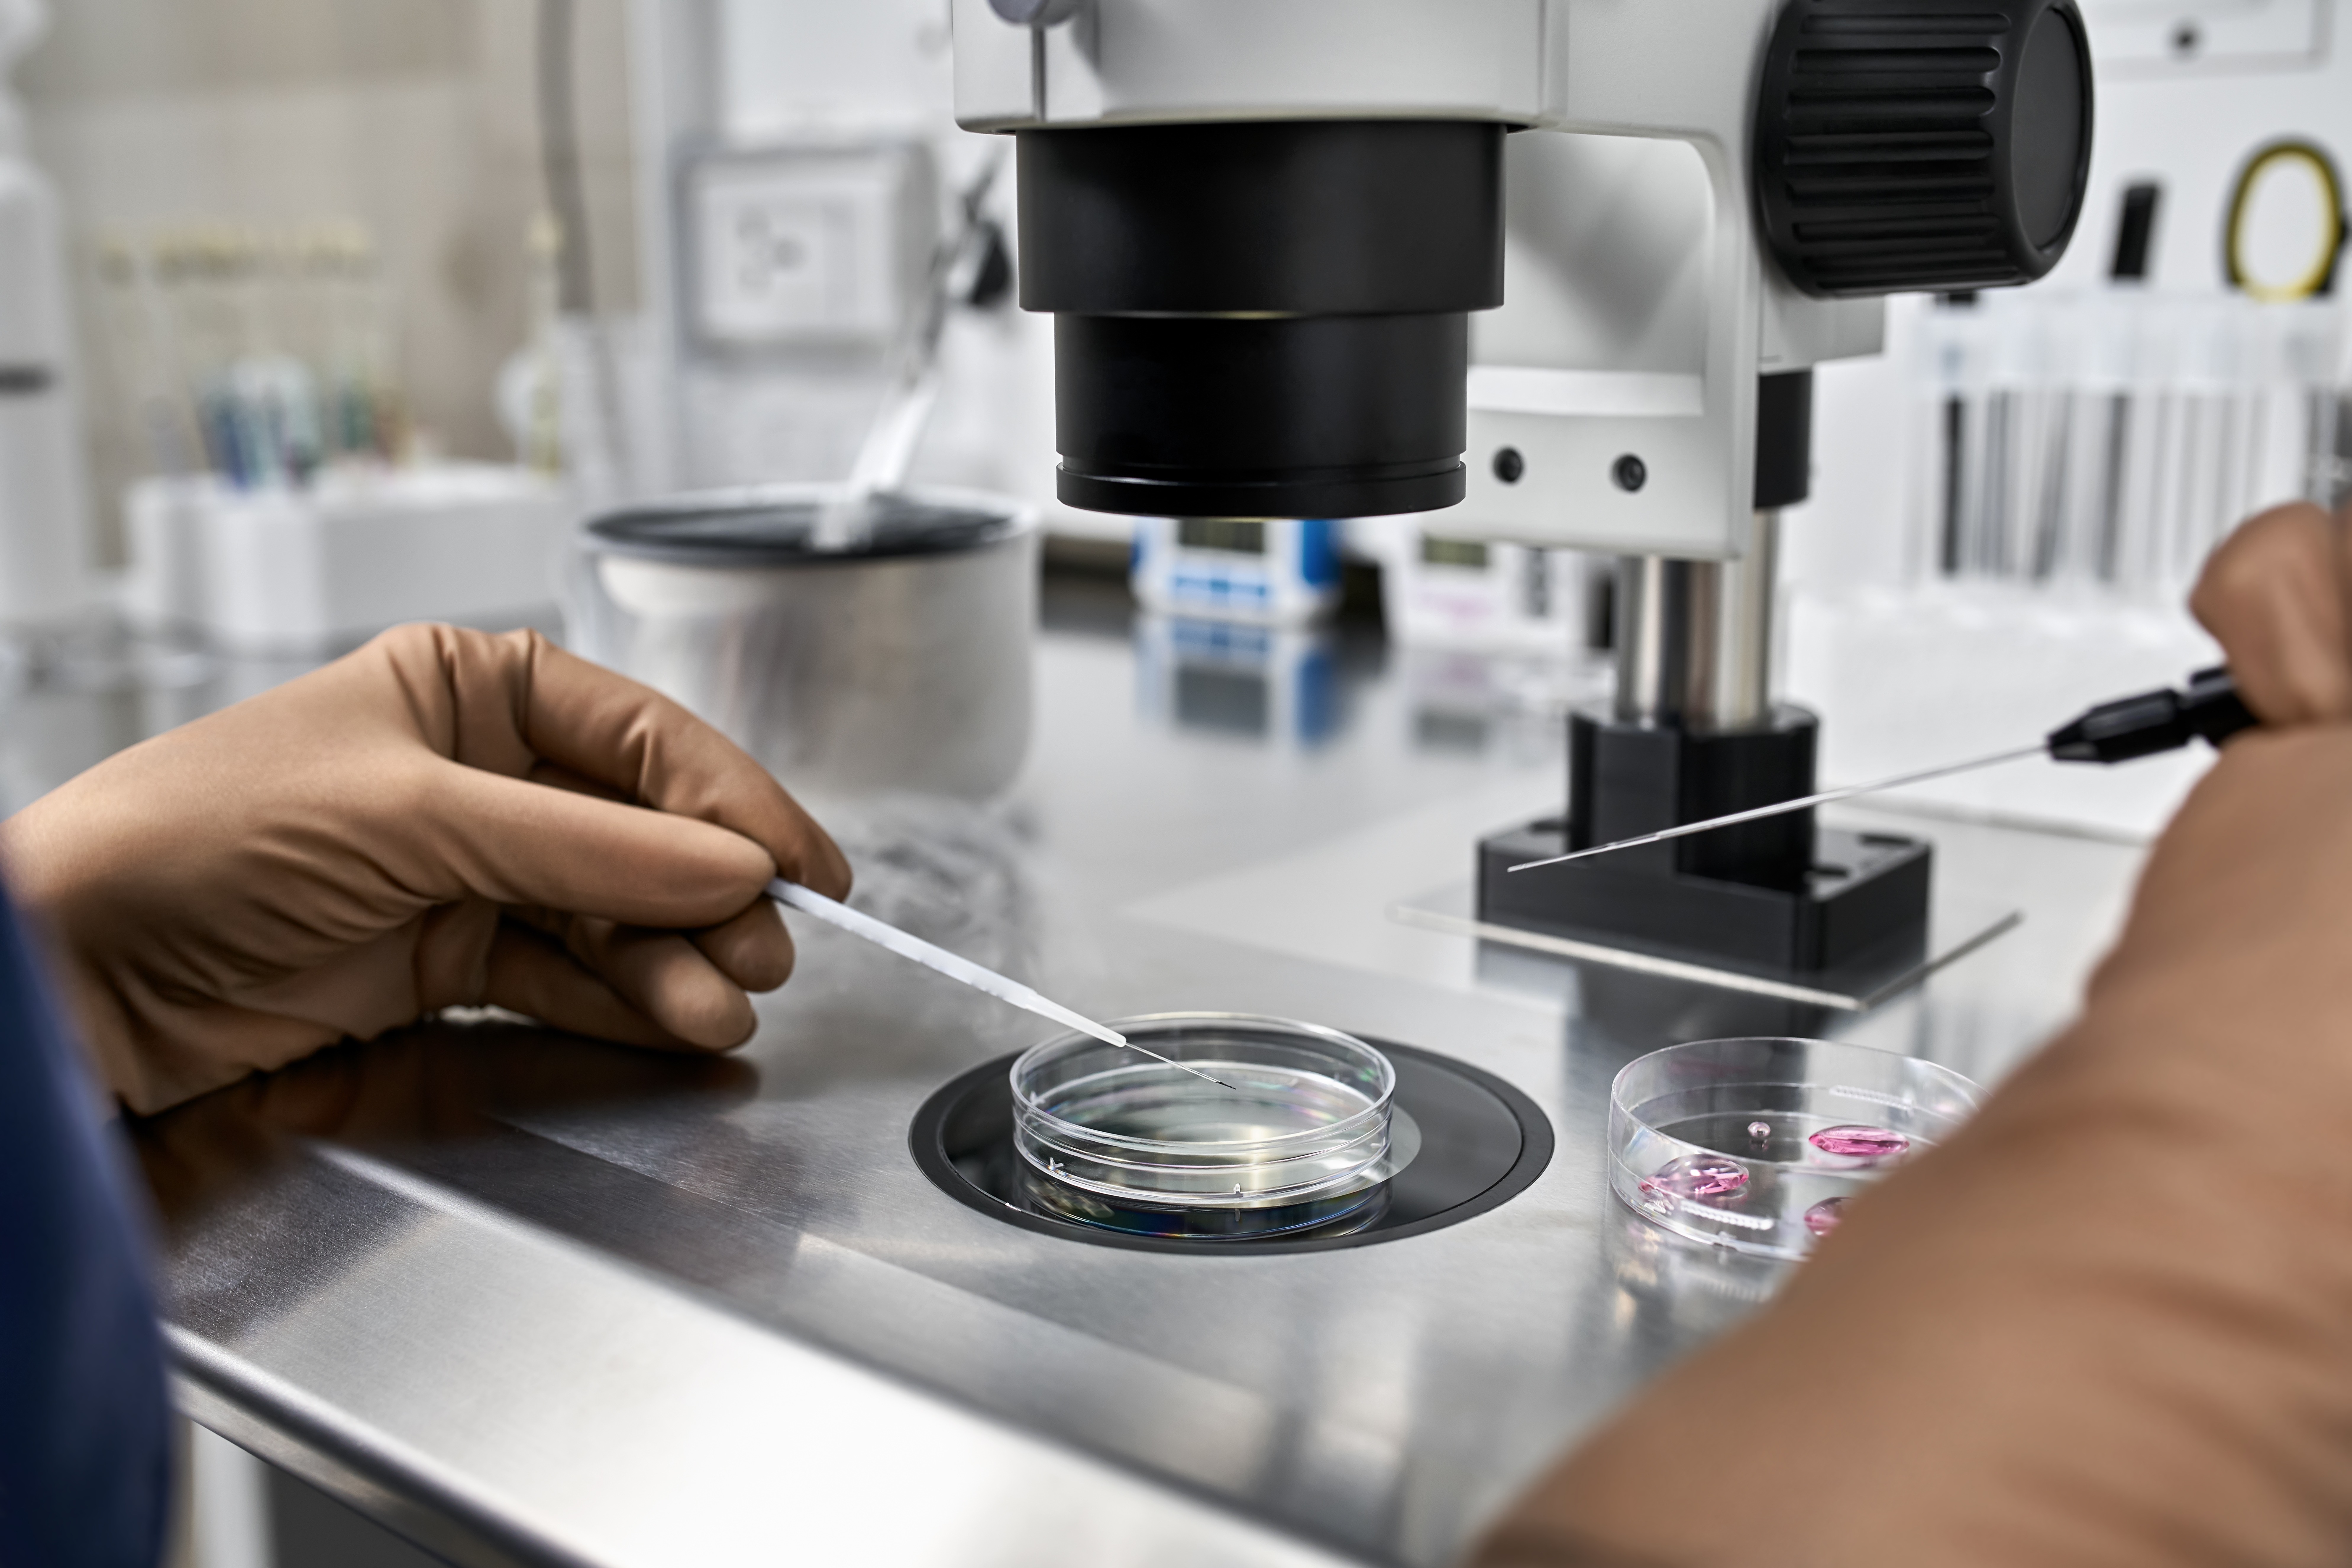

Como se preparar para iniciar o tratamento de Reprodução Humana Assistida?
A primeira consulta é um momento muito importante para os pacientes que buscam na reprodução humana uma possibilidade de realizar o sonho de ter filhos.
Por isso, a ansiedade é muito comum neste período e surgem diversas dúvidas sobre a consulta, as principais dúvidas são: posso ir sozinha na consulta ou meu marido precisa estar? Quais exames devo fazer? A consulta pode ser online? Qual o tempo total do tratamento? Na primeira consulta já devo pagar o tratamento?
Vamos buscar neste artigo tirar as principais dúvidas.

O ideal é que o casal esteja na consulta, para que possam esclarecer todas as dúvidas, mas na impossibilidade de ambos estarem, não é um problema estar apenas um dos parceiros. Quanto aos exames, sempre indicamos que tragam os exames que já tiverem realizado, independente da data em que foram efetuados. Os que puderem ser aproveitados, o médico utilizará e solicitará que refaça os que forem necessários.
A primeira consulta pode ser online ou presencial, o que for mais adequado para os pacientes. No momento de retorno e exame físico, precisa ser presencial.
O tempo irá depender de qual tratamento será realizado. No geral, a média de 20 a 30 dias.
E sobre o pagamento do tratamento, ele não é tratado já na primeira consulta, uma vez que nela apenas se inicia e definição de qual procedimento será indicado. Quando tudo estiver definido, então o pagamento será realizado no início do tratamento.
Importante ressaltar que no Projeto Beta, o paciente tem 3 meses para retornar à consulta com os exames, sem custo adicional.
Agora que já falamos sobre a primeira consulta, quais dicas para o retorno? O que o paciente pode fazer para agilizar o seu tratamento?
Dicas para a consulta de retorno

O primordial no retorno é trazer os exames solicitados pelo médico especialista. Além de analisar os resultados dos exames, nesta consulta o médico também realiza ultrassom, como parte do exame físico e orienta efetivamente qual será o tratamento, dose de medicação para estimular a ovulação. Portanto, após a consulta já é possível ter o orçamento exato do tratamento.
Eventualmente poderão ser receitadas vitaminas para que a paciente tome durante o tratamento, mas cada tratamento é individualizado, então não existe uma regra aplicável a todos, o médico irá verificar a necessidade de cada pessoa. Na maioria dos casos as vitaminas recomendadas são Ogestan pré e vitamina D. Outros ajustes são recomendados como evitar consumo de bebidas alcoólicas, fumar e comer alimentos pouco saudáveis. Este conjunto de ações são tentativas importantes para corrigir desequilíbrios nutricionais e otimizar as chances de sucesso no tratamento.
Então após a consulta de retorno a paciente já poderá ter uma definição de qual tratamento irá seguir, assinar os contratos, iniciar medicações e uma boa e equilibrada rotina alimentar para iniciar o seu tratamento.
Quais opções de tratamentos?
Os principais tratamentos realizados para quem está buscando engravidar são a Inseminação Intra Uterina (IIU), também conhecida como Inseminação Artificial e a Fertilização In Vitro conhecida pela sigla FIV. Além desses, também existe procedimentos que por suas características e eficiência são indicados com menor frequência, como a Mini-FIV e o Coito Programado.
A escolha de um procedimento de reprodução assistida depende de muitos fatores, como a condição do casal, hétero ou homoafetivo, ou ainda se são indivíduos solteiros que desejam ter filhos. A escolha entre estes procedimentos depende do caso e dos resultados dos diversos testes e estudos realizados pelo especialista em reprodução assistida. Não há um método melhor do que outro, mas simplesmente opções diferentes que podem ser mais eficientes para cada condição, indivíduo ou pessoas.
A Inseminação Artificial (Inseminação Intrauterina) é uma técnica de reprodução assistida simples e de baixa complexidade, considerada pouco invasiva. Geralmente, é o primeiro passo nas tentativas de solucionar os problemas de fertilidade, embora como dissemos anteriormente, vai depender das causas e condições de cada paciente, já que necessita que as funções e anatomia das trompas estejam normais.
Já a Fertilização In Vitro (FIV) consiste na extração dos óvulos de uma mulher para realizar a fertilização em laboratório e, em seguida, realizar a transferência do embrião para a cavidade do útero. É uma técnica mais complexa que a Inseminação Artificial, pois requer entre seus passos, a realização de uma punção ovariana transvaginal para a aspiração do líquido folicular, sendo realizada com sedação leve.
Já a Fertilização In Vitro (FIV) consiste na extração dos óvulos de uma mulher para realizar a fertilização em laboratório e, em seguida, realizar a transferência do embrião para a cavidade do útero. É uma técnica mais complexa que a Inseminação Artificial, pois requer entre seus passos, a realização de uma punção ovariana transvaginal para a aspiração do líquido folicular, sendo realizada com sedação leve.
Temos um artigo completo explicando as principais diferenças entre os tratamentos, (clique aqui para ler).
Resultados
A FIV oferece melhores resultados com relação aos demais tratamentos, por isso, é o procedimento mais realizado no Projeto Beta. Mas por ser um procedimento mais complexo, também tem o custo maior do que outros procedimentos como a Inseminação Artificial e o Coito Programado.
Além destes procedimentos citados, também é muito importante falarmos sobre um outro procedimento de excelência e que visa preservar a fertilidade da mulher, o Congelamento ou Vitrificação de Óvulos.

Cada vez mais as mulheres adiam os planos de maternidade seja por questões financeiras, profissionais ou simplesmente por não ser o momento ideal. Mas a fertilidade da mulher diminui muito após os 35 anos, por isso, se você não quer engravidar no momento, mas quer resguardar sua fertilidade e suas chances de gestação em alguns anos, realize o congelamento de óvulos.
Esperamos que este artigo tenha sido esclarecedor e que possa auxiliar você a se preparar para os primeiros passos do seu tratamento de reprodução humana assistida. Caso tenha ficado com alguma dúvida, entre em contato conosco!
Conte com o Projeto Beta para auxiliar na realização do seu sonho!
Categoria: Blog
Publicado em: 22/11/2022
